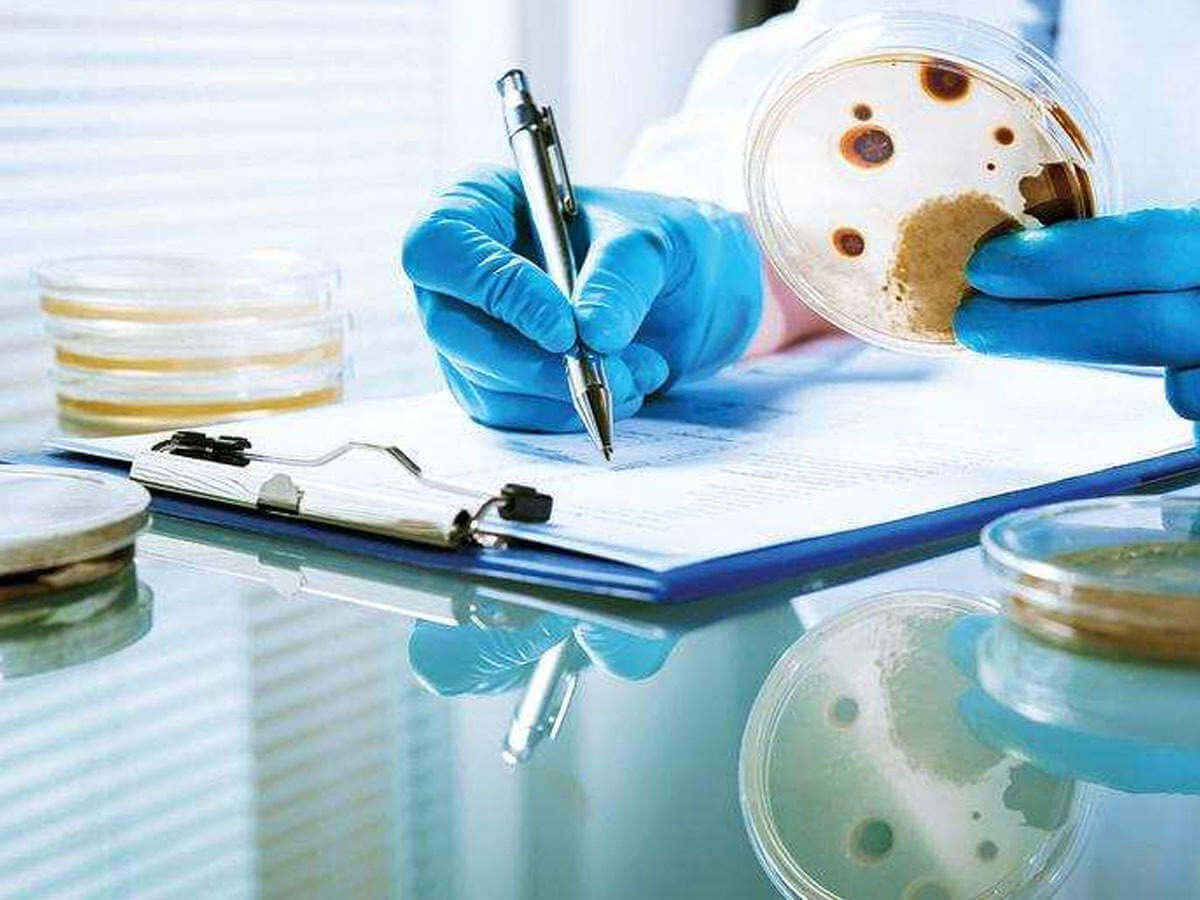
Telangana govt declares 'black fungus' mucormycosis notifiable disease under Epidemic Diseases Act

Arunachal Pradesh: Questioning the Integrity of APPSC Appointments in Light of Constitutional Mandates
Admin 13 Dec, 23 0 207
Arunachal media outraged over exclusion from APPSC swearing-In ceremony, slams Government for suppressing Press Freedom
Admin 13 Dec, 23 0 207
India becomes the second largest mobile manufacturing country: 2 billion domestically assembled smartphones and feature phones were shipped between 2014 and 2022 as part of its 'Make in India' initiative.
Admin 17 Aug, 23 0 230